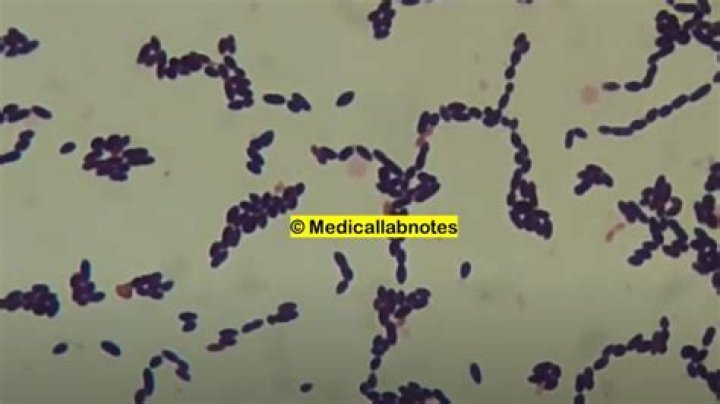

Is Enterococcus faecium harmful or helpful

Andrew Campbell
Published Mar 23, 2026
faecium may be pathogenic and harmful to humans, and can cause bacteraemia, endocarditis, urinary tract and other infections. Moreover, anti-microbial resistance (AMR) to many commonly used antibiotics has been reported, and E. faecium is the leading cause of multi-drug resistant enterococcal infections in humans.
Is Enterococcus faecium good or bad?
E. faecalis bacteria don’t usually cause problems in healthy people. But people with underlying health conditions or a weakened immune system are more likely to get sick. These infections often spread in hospitals.
Is Enterococcus faecalis a good bacteria?
E. faecalis has both natural and acquired immunity from antibiotic treatment. As a result, it is one of the most antibiotic-resistant types of bacteria. The bacteria can also tolerate a variety of conditions.
What is Enterococcus faecium good for?
faecium and E. faecalis strains are used as probiotics and are ingested in high numbers, generally in the form of pharmaceutical preparations. Such probiotics are administered to treat diarrhoea, antibiotic-associated diarrhoea or irritable bowel syndrome, to lower cholesterol levels or to improve host immunity.Is Enterococcus faecium a contaminant?
While, in most instances, Enterococcus species in positive blood cultures represents true BSI, studies have found that Enterococcus species may be a contaminant in blood cultures in 10–15 % of cases [3, 5].
Is Enterococcus faecium safe for dogs?
Enterococcus faecium can provide several benefits to a pet including, aiding digestion and helping to maintain a healthy mix of bacteria in the stomach, which can be helpful when switching diets or after antibiotic treatment.
Does AOR probiotic 3 need to be refrigerated?
Easy to Take and to Store It is room-temperature stable and does not need to be refrigerated to maintain its potency, making it ideal for travelers to tropical places where the risk of gastroenteritis is the highest.
How is Enterococcus faecium treated?
Linezolid, an oxazolidinone antibiotic, is available orally and intravenously and is used to treat infections caused by E faecium and E faecalis strains, including VRE.Is Enterococcus faecium safe for cats?
Currently, only Enterococcus faecium NCIMB 10415 and Enterococcus faecium DSM 10663/NCIMB 10415 have been approved for use as food additives in dogs and cats by the European Food Safety Authority (EFSA).
Is Enterococcus faecalis the same as Enterococcus faecium?Infections due to Enterococcus faecalis tend to be more virulent than infections due to Enterococcus faecium. In addition, bacteremia due to E. faecalis is more likely to be associated with endocarditis than bacteremia due to E. faecium.
Article first time published onWhat is Enterococcus faecium infection?
Enterococcus faecalis and E. faecium cause a variety of infections, including endocarditis, urinary tract infections, prostatitis, intra-abdominal infection, cellulitis, and wound infection as well as concurrent bacteremia. Enterococci are part of the normal intestinal flora.
Is Enterococcus faecium archaebacteria or eubacteria?
Enterococcus faeciumScientific classificationDomain:BacteriaPhylum:”Firmicutes”Class:Bacilli
Is enterococcus the same as E coli?
Results indicated that enterococci might be a more stable indicator than E. coli and fecal coliform and, consequently, a more conservative indicator under brackish water conditions.
Is Enterococcus faecalis motile?
Enterococcus faecalis is a non-motile, facultative anaerobic bacterium that inhabits the human gastrointestinal (GI) tract [1].
Is Enterococcus faecalis coagulase positive or negative?
The most frequent Gram-positive cocci were methicillin-resistant coagulase-negative staphylococcus (CoNS, 46 isolates), methicillin-resistant Staphylococcus aureus (MRSA, 13) and enterococcus (34, E. faecium 30, E. faecalis 4).
Is Enterococcus faecalis Gram-positive or negative?
Enterococcus faecalis is a gram-positive bacterium that can cause a variety of nosocomial infections of which urinary tract infections are the most common. These infections can be exceptionally difficult to treat because of drug resistance of many E. faecalis isolates.
Is Bio complete 3 FDA approved?
Though you should still talk to your healthcare provider before taking any new supplements, Bio Complete 3 is generally recognized as safe. While the health claims made by Gundry MD haven’t been examined by the FDA, the ingredients in this supplement are FDA-approved.
What are active probiotics?
Probiotics are live bacteria and yeasts that are good for you, especially your digestive system. We usually think of these as germs that cause diseases. But your body is full of bacteria, both good and bad. Probiotics are often called “good” or “helpful” bacteria because they help keep your gut healthy.
What is dry Enterococcus faecium Fermentation in dog food?
Dried Enterococcus Faecium Fermentation Product A probiotic, or good bacteria, that is added to our formulas to help support healthy digestion.
Can dogs get enterococcus?
In healthy dogs and cats, enterococci can be found on the skin and within the oral cavity, nasal cavity, and gastrointestinal tract. In the United States, the most prevalent species in dogs appears to be E. faecalis, which comprised 68% of 155 isolates.
What is dried Bifidobacterium Animalis fermentation product?
Dried Bifidobacterium Animalis Fermentation Product A probiotic, or good bacteria, that is added to our formulas to help support healthy digestion. It is a component of our proprietary probiotic blends, K9 Strain Probiotics and Viables Probiotics.
What is lactic acid microorganisms in dog food?
Lactic acid-producing bacteria are the most commonly used probiotics in foods. It is well known that probiotics have a number of beneficial health effects in humans and animals. They play an important role in the protection of the host against harmful microorganisms and also strengthen the immune system.
What are tocopherols in dog food?
Mixed Tocopherols are a natural preservative used in dog food to slow dog spoilage. Tocopherols are a family of vitamin E compounds naturally found in vegetable oils, nuts, fish and leafy green vegetables.
What is pyridoxine hydrochloride in dog food?
Pyridoxine hydrochloride is the most common form used when supplementing pet foods with the B-vitamin pyridoxine. Pyridoxine is very important in helping the pet metabolize protein.
Does Enterococcus faecalis cause diarrhea?
Enterococcus faecalis is a commensal organism of the intestinal tract. However, it may be a causative agent of diarrhea in elderly and immunocompromised patients.
Is ampicillin good for urinary tract infections?
Ampicillin is used to treat certain infections that are caused by bacteria such as meningitis (infection of the membranes that surround the brain and spinal cord); and infections of the throat, sinuses, lungs, reproductive organs, urinary tract, and gastrointestinal tract.
What antibiotic kills Enterococcus?
If the organism is susceptible, ampicillin is the drug of choice. Vancomycin can be used if the organism is ampicillin-resistant. Linezolid or quinupristin/dalfopristin are reasonable alternatives if the enterococcus is resistant to both ampicillin and vancomycin.
How does Enterococcus faecalis differ from Enterococcus faecium?
faecalis can grow on mannitol salt agar and ferment mannitol, while E. faecium lacks these phenotypes. These data reveal that we now have rapid, cost effective ways to identify enterococci to the species, and not just genus, level and have significance for patient treatment in hospitals.
Is Enterococcus faecalis a UTI?
Enterococcus faecalis is a gram-positive bacterium that can cause a variety of nosocomial infections of which urinary tract infections are the most common. These infections can be exceptionally difficult to treat because of drug resistance of many E. faecalis isolates.
Does Levaquin treat Enterococcus faecalis?
LEVAQUIN® is indicated in adult patients for the treatment of complicated urinary tract infections (mild to moderate) due to Enterococcus faecalis, Enterobacter cloacae, Escherichia coli, Klebsiella pneumoniae, Proteus mirabilis, or Pseudomonas aeruginosa [see Clinical Studies].
What is the most common site for enterococci infections?
The most common type of enterococcal infection occurs in the urinary tract. Lower urinary tract infections (such as cystitis, prostatitis, and epididymitis) are frequently seen in older men.



